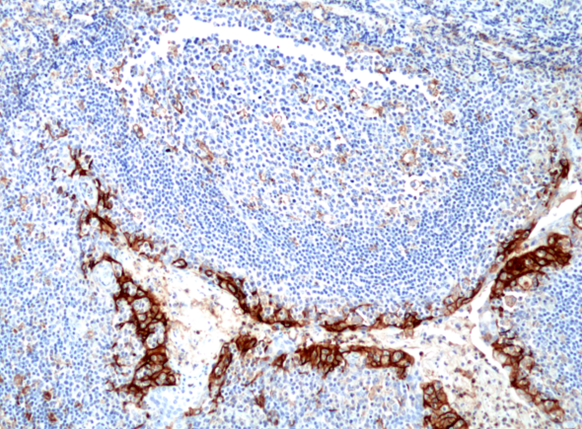

八一军旗,猎猎飘扬!今天,我们向保卫祖国安宁的英雄儿女致敬!当钢铁洪流铸就国防长城,微观世界正上演另一场生死守卫战!在生命的疆域里,同样存在着一支沉默却至关重要的“防卫军”——我们的免疫系统。RevMAb以革命性抗体技术锻造“生物导弹”,致敬人体免疫系统——这支与生俱来的“生命卫队”!
▌人体如国度,免疫系统是忠诚的国防部队:
-
皮肤黏膜:战壕堡垒(物理屏障);
-
吞噬细胞:先锋尖兵(快速反应);
-
T/B细胞:特种作战单元(精准歼敌);
▌而最狡猾的敌人——肿瘤细胞,精通“伪装潜行”:
-
PD-L1靶标:癌细胞竖起“伪停战旗”,阻断T细胞攻击信号;
-
BRAF V600E突变:激活癌基因“叛乱信号”,驱动肿瘤疯狂增殖;
-
组蛋白H3.3突变:改写细胞“遗传密码”,诱发骨肉瘤等侵袭性病变。
▌人PD-L1抗体(克隆号RM320)——免疫哨兵
战术价值:锁定肿瘤“伪停战旗”,为免疫治疗提供导航;
技术突破:独家表位定位技术,灵敏度达单细胞级(稀释1:1000仍强度+++显色);开发验证过程中与金标准抗体22C3高一致性,杜绝“情报失误”。
使用抗PD-L1兔单克隆抗体克隆RM320对福尔马林固定和石蜡包埋的人扁桃体组织切片进行免疫组织化学染色。
▌BRAF V600E抗体(克隆号RM8)——信号拦截系统
战术价值:捕获黑色素瘤/结直肠癌的“叛变信号”,突变丰度低仍可检出;
技术突破:独家兔单抗设计,避免与野生型BRAF交叉反应(假阳性率<0.1%)。

使用抗BRAF V600E兔单克隆抗体克隆RM8对福尔马林固定和石蜡包埋的甲状腺癌组织进行免疫组织化学染色。
▌组蛋白H3.3突变抗体组(克隆号Clone RM191, RM192, RM193, RM363, RM263, RM240, RM307)——基因纠察队
战术价值:精准识别骨巨细胞瘤/儿童胶质瘤的G34W/R/V突变,突破性区分野生型与突变型,杜绝“敌我误判”;
技术突破:三重突变同步检测,精准识别超稳定。

使用抗组蛋白 H3.3 G34W 抗体克隆 RM263 对巨细胞骨肿瘤 (GCBT) 组织切片进行免疫组织化学染色。图片由Adrienne Flanagan, Department of Histopathology, RONH, Stanmore, Middlesex, UK提供。

使用 RM193 抗组蛋白 H3 K36M mAb对福尔马林固定石蜡包埋 (FFPE) 软骨母细胞瘤肿瘤组织切片进行免疫组织化学染色。图片由Adrienne Flanagan, Department of Histopathology, RONH, Stanmore, Middlesex, UK提供。
▌值此建军98周年,恩瑞科特惠提供"弹药补给":
-
20ul小包装特价活动持续升温,产品清单详见:【快速查询】400多种爆款20μL抗体产品
-
上百款100ul标准装抗体现货促销
RevMab“精准制导抗体”:破译肿瘤伪装术,守护生命防线,我们恩瑞科以科技之力致敬中国军人——同样的忠诚守护,不同的战场荣光!
Post time: 2025-08-01 17:44:04
- Previous: 幽门螺杆菌检测,RevMAb多款兔单克隆抗体,解决检测核心痛点。
- Next: 有没有骨气? arigo 教你测!
